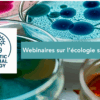

Dans le cadre du projet “Les arches de la biodiversité de TBI” (détails en fin de message), vous êtes invités à venir planter les premières plantes grimpantes qui devraient dans quelques temps recouvrir les structures métalliques de la façade sud de TBI.
Cette plantation aura lieu le jeudi 11 décembre de 15h à 16h30 et sera suivie d’un café partagé.
Si vous souhaitez participer à cette plantation merci de vous inscrire : https://framadate.org/jr3bTUl5yzSCyB2E
Nous profitons de ce message pour remercier celles et ceux qui ont rempli le questionnaire “Place de la nature à TBI et impact sur la qualité de vie au travail”. Une présentation des résultats de ce questionnaire sera diffusée prochainement au sein du laboratoire.
Très bonne journée.
Sandrine Uttenweiler et Sandrine Laguerre (référentes Transition Ecologique TBI)
Détails sur le projet
————————-
« Les arches de la biodiversité » est un projet de végétalisation du bâtiment principal de TBI (bâtiment 39-MB3 sur le campus de l’INSA de Toulouse) financé par le CNRS, l’INSA et TBI.
Ce projet vise à installer des structures métalliques en forme d’arches pour amener des plantes grimpantes du sol aux grilles de la façade d’entrée du bâtiment. Son objectif principal est de favoriser la biodiversité en offrant un habitat aux insectes et araignées qui pourront servir de nourriture aux oiseaux. La végétalisation de la façade sud de ce bâtiment, qui a un aspect plutôt industriel pour l’instant, s’inscrit dans le cadre d’un projet global de re-végétalisation du campus de l’INSA de Toulouse auquel TBI et le CNRS ont souhaité s’associer. L’impact de cette re-végétalisation sera étudié du point de vue de la biodiversité, de la qualité de vie au travail, de la perception de la biodiversité, de la lutte contre les ilots de chaleur et dans une moindre mesure et à plus longue échéance en termes d’économies d’énergie.